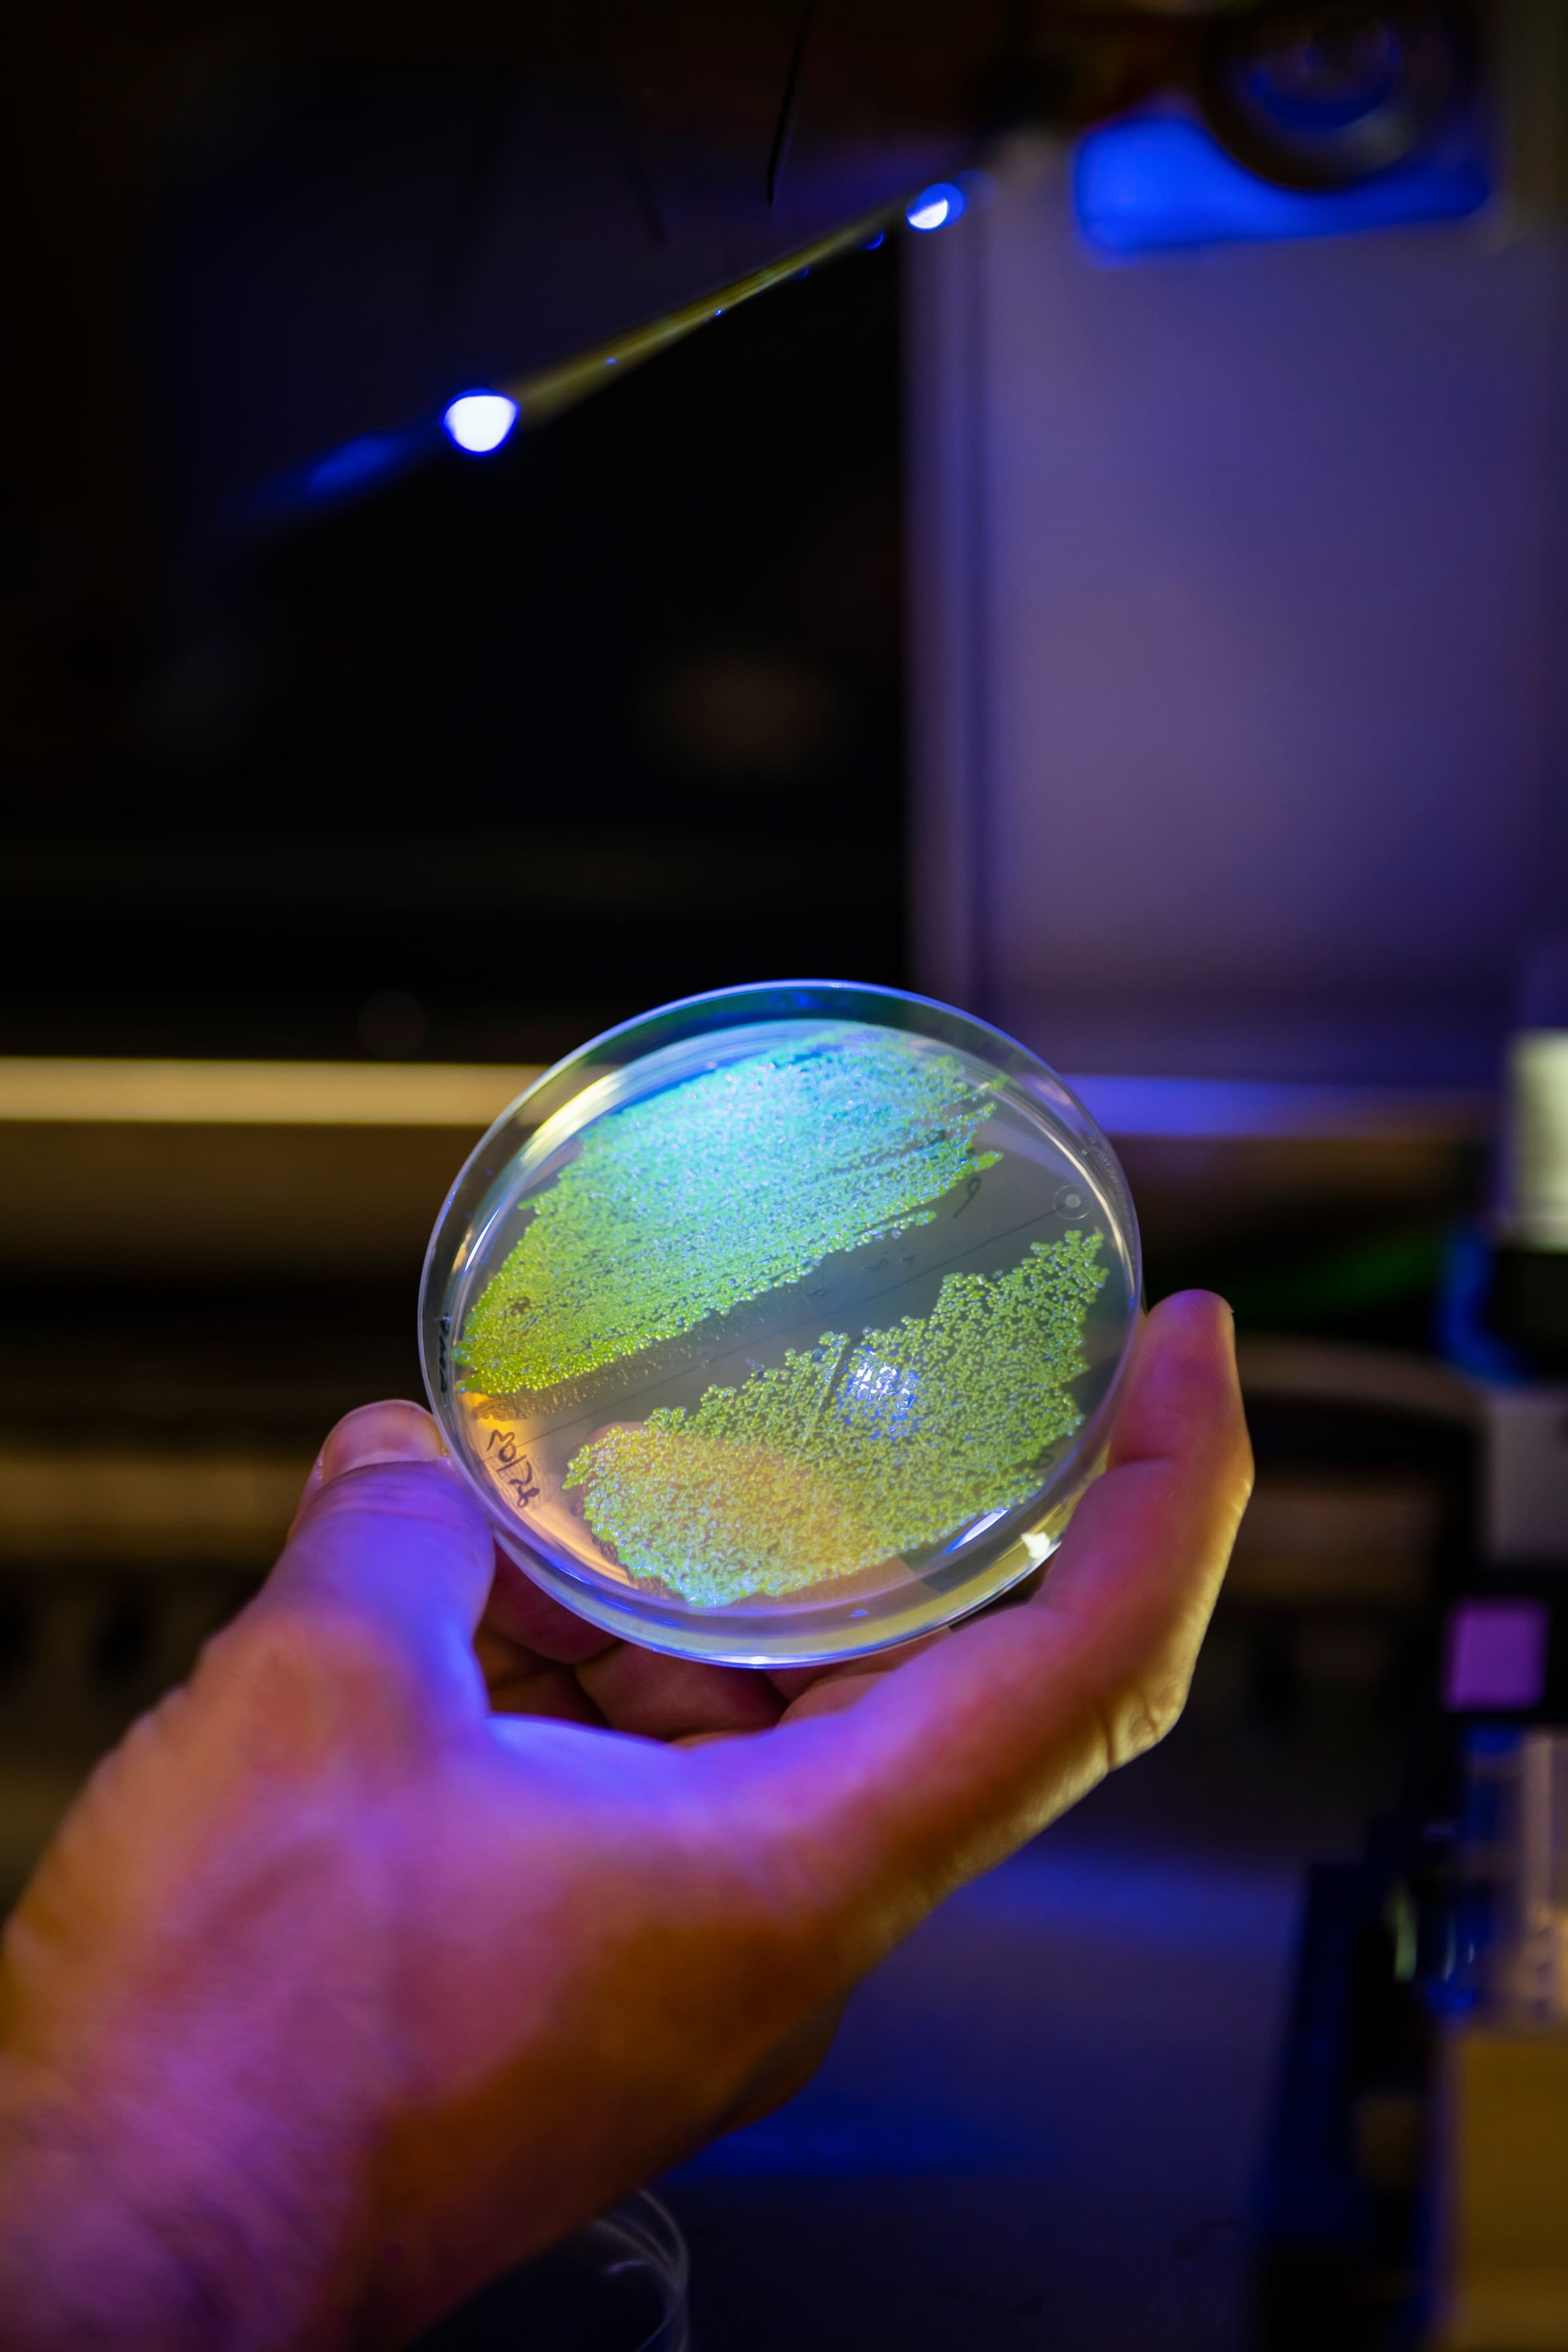
header

Fermentation & microbial solutions are opening a new era in therapeutics: more precise, efficient, and sustainable.



At Abolis Biotechnologies, we develop biotech-powered cosmetic ingredients meet consumer demands, combining high-performance, safety and sustainability.

To support global nutrition sustainably, we need to innovate and provide advanced ingredients.



The specialty and fine chemicals industry faces growing pressure to: Increase bio-based content, reduce greenhouse gas emissions, maintain product quality and performance, managing complex supply chains and evolving regulations.